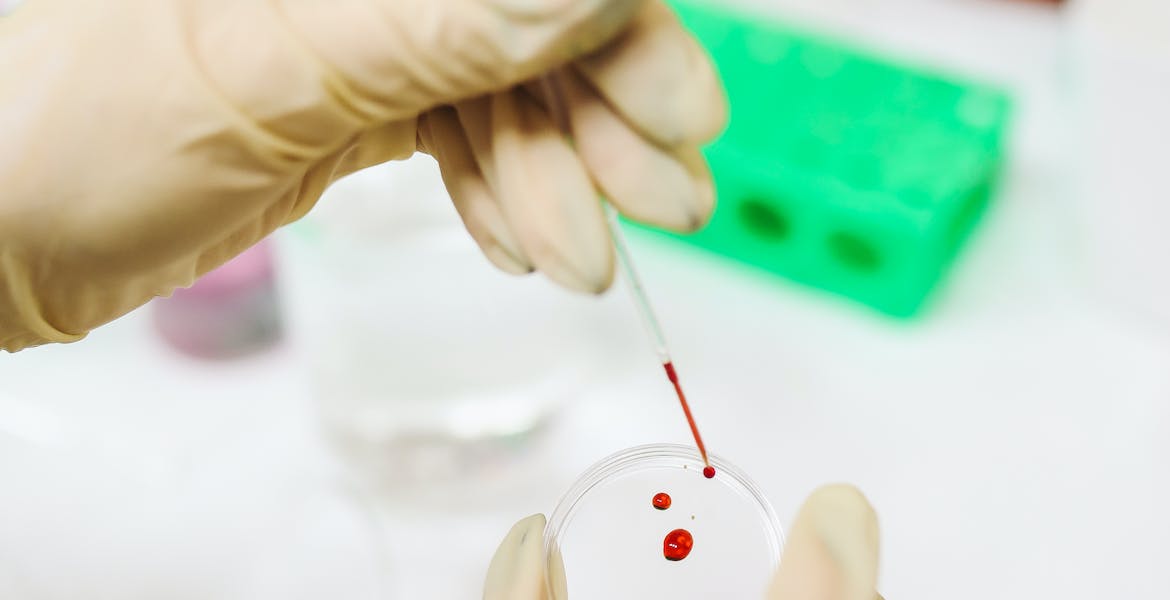
Image

No of Donors
120+
No of Beneficiaries
4000+
Recent Comments
Recent Posts
-
Hello world!
November 3, 2023 -

Marketing tips for early-stage startups
January 19, 2021 -

How agencies can prepare for the future with AI
January 19, 2021
Categories
- Branding 2
- Corporate 1
- Creative 3
- Design 3
- It Solution 2
- Uncategorized 1

